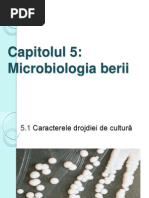

0% au considerat acest document util (0 voturi)
128 vizualizări8 paginiReferat Berea
Documentul prezintă procesul de fabricare a berii, cu accent pe microbiologia implicată. Descrie drojdiile folosite la fermentare (Saccharomyces carlsbergensis și Saccharomyces cerevisiae), sursele potențiale de contaminare microbiologică de-a lungul procesului (materii prime, apă, ambalaje, echipamente) și microbiota specifică și nespecifică implicată.
Încărcat de
Gianina Madalina SachelaruDrepturi de autor
© © All Rights Reserved
Respectăm cu strictețe drepturile privind conținutul. Dacă suspectați că acesta este conținutul dumneavoastră, reclamați-l aici.
Formate disponibile
Descărcați ca DOCX, PDF, TXT sau citiți online pe Scribd
0% au considerat acest document util (0 voturi)
128 vizualizări8 paginiReferat Berea
Documentul prezintă procesul de fabricare a berii, cu accent pe microbiologia implicată. Descrie drojdiile folosite la fermentare (Saccharomyces carlsbergensis și Saccharomyces cerevisiae), sursele potențiale de contaminare microbiologică de-a lungul procesului (materii prime, apă, ambalaje, echipamente) și microbiota specifică și nespecifică implicată.
Încărcat de
Gianina Madalina SachelaruDrepturi de autor
© © All Rights Reserved
Respectăm cu strictețe drepturile privind conținutul. Dacă suspectați că acesta este conținutul dumneavoastră, reclamați-l aici.
Formate disponibile
Descărcați ca DOCX, PDF, TXT sau citiți online pe Scribd